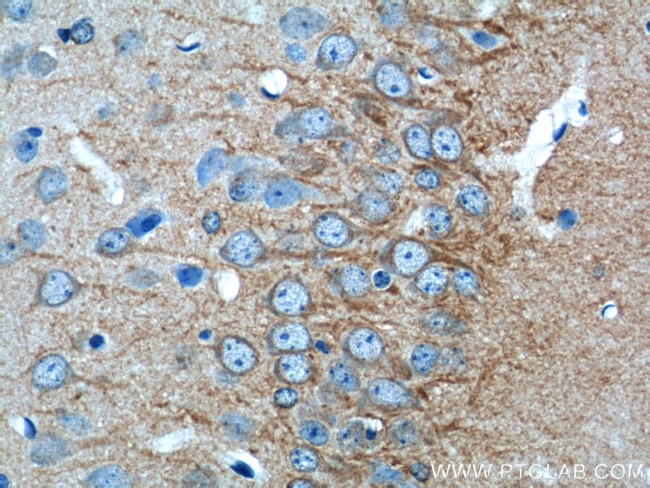
CACNG2 Antibody in Immunohistochemistry (Paraffin) (IHC (P))

Search
Proteintech
CACNG2 Polyclonal Antibody
{{$productOrderCtrl.translations['antibody.pdp.commerceCard.promotion.promotions']}}
{{$productOrderCtrl.translations['antibody.pdp.commerceCard.promotion.viewpromo']}}
{{$productOrderCtrl.translations['antibody.pdp.commerceCard.promotion.promocode']}}: {{promo.promoCode}} {{promo.promoTitle}} {{promo.promoDescription}}. {{$productOrderCtrl.translations['antibody.pdp.commerceCard.promotion.learnmore']}}
产品信息
20969-1-AP
种属反应
宿主/亚型
分类
类型
抗原
偶联物
形式
浓度
规格
纯化类型
保存液
内含物
保存条件
运输条件
靶标信息
Stargazin is a member of the transmembrane AMPAR regulatory proteins (TARP) family and is involved in glutamate receptor trafficking. It has been recently demonstrated that the interaction between stargazin and AMPA receptors is critical for the correct localization of the receptors at the synapse. Phosphorylation of the stargazin protein at Thr 321 by Protein Kinase A regulates its interaction with PSD-95 and synaptic targeting of AMPA receptors.
仅用于科研。不用于诊断过程。未经明确授权不得转售。
篇参考文献 (0)
生物信息学
蛋白别名: CACNG2; CaV gamma 2; MGC123981; MGC138502; MGC138504; Neuronal voltage-gated calcium channel gamma-2 subunit; Stargazin; TARP; TARP gamma 2; TARP gamma-2; Transmembrane AMPAR regulatory protein gamma-2; Voltage-dependent calcium channel gamma-2 subunit
基因别名: AW060990; B230105C07Rik; B930041E13Rik; CACNG2; MRD10; stargazer; stargazin; Stg; wag; waggler
UniProt ID: (Human) Q9Y698, (Mouse) O88602
Entrez Gene ID: (Human) 10369, (Mouse) 12300